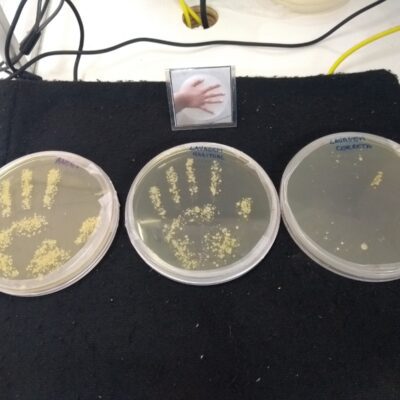
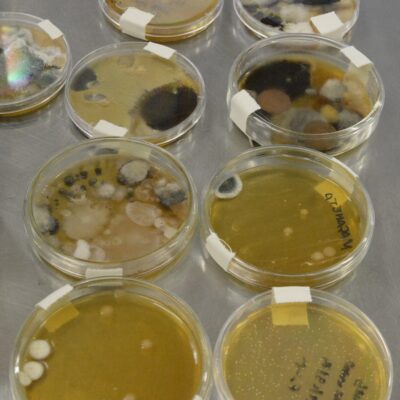

Ações de Extensão
Fernanda de Avila Abreu
O projeto tem como objetivo a apresentação de temas relacionados à Microbiologia a alunos do ensino fundamental e médio de escolas públicas e integrantes de suas famílias, de forma a quebrar mitos e esclarecer questões do cotidiano. Os conceitos apresentados no curso são: (1) a definição de microrganismos; (2) onde são encontrados; (3) sua importância para o homem; (4) a participação dos microrganismos em processos naturais; (5) a participação dos microrganismos em processos industriais; (6) a participação dos microrganismos na doença; (7) procedimentos ideais no manuseio de alimentos e de higiene que contribuem para a manutenção da saúde familiar. Durante o projeto os alunos serão estimulados a desenvolver experimentos simples para demonstração da presença de microrganismos em todos os ambientes, da participação dos microrganismos na produção de alimentos e da eficiência de processos de desinfecção e esterilização utilizados no cotidiano familiar. Ao final do projeto os alunos apresentarão os temas abordados nos experimentos para seus familiares. Nos últimos anos, devido a restrições orçamentárias, as atividades lúdicas foram incluídas nas atividades do projeto, nas quais jogos com embasamento científico, desenvolvidos por alunos de graduação da UFRJ, são utilizados como ferramentas de diversão e apropriação do conhecimento científico.
Links:
https://www.instagram.com/cienciaemjogoufrj/
https://www.facebook.com/CienciaEmJogo/
Coordenador: Marco Antonio Lemos Miguel
E-mail: marco.miguel@micro.ufrj.br
O aluá é uma bebida produzida a partir da fermentação do abacaxi, milho, arroz ou pão. Sua origem é atribuída aos povos indígenas sul-americanos e africanos. Por se tratar de uma bebida naturalmente carbonatada, foi considerada o primeiro refrigerante brasileiro, com o auge de seu consumo no período do Brasil colonial, onde era consumido em festas, residências ou comercializadas nas ruas do Rio por negros escravizados. Entretanto, sua popularidade caiu drasticamente com a chegada das bebidas industrializadas ao Brasil. Este projeto tem como objetivo resgatar e difundir conhecimento sobre as origens e importância histórica do aluá, além de valorizar a cultura de povos tradicionais relacionados à história da bebida e estimular a difusão de sua produção e consumo. Esta atitude vai de encontro às recomendações do Ministério da Saúde, através do Guia Alimentar para a População Brasileira, que estimula a participação do consumidor na produção de seu alimento, além da utilização integral dos alimentos, como cascas e talos, que ajudam a reduzir a geração de resíduos. Outro aspecto a ser valorizado serão as propriedades nutricionais e potencialmente probióticas da bebida. A divulgação das informações será realizada pela produção de conteúdo como a edição de um livro, criação de um vídeo de curta-metragem sobre o aluá, palestras em escolas, centros comunitários e ambientes culturais. O conteúdo também será difundido em redes sociais e apresentações em eventos científicos e culturais.
Coordenadora: Bernadete Teixeira Ferreira Carvalho
E-mail de contato: bernadete@micro.ufrj.br
O projeto visa divulgar a correta técnica de lavagem de mãos e a importância desse hábito no dia-a-dia de crianças que frequentam o ambulatório do hospital infantil da UFRJ e suas famílias. Durante as atividades do projeto, estes lavam as mãos e pelo uso prévio de um composto que fluoresce sob a luz negra comprovamos se a técnica foi realizada corretamente. Em seguida, o público-alvo recebe informações sobre a técnica correta para realizar a lavagem de mãos e sobre a importância do seu uso diário na prevenção de infecções veiculadas pelas mãos. É demonstrado em placas contendo meio de cultivo o crescimento de microrganismos originários das mãos antes e após a lavagem, e de superfícies de contato com estas, como maçanetas, utensílios e brinquedos. As crianças e seus responsáveis entram em contato com o mundo dos microrganismos e realizam uma série de atividades lúdicas que visam demonstrar a presença de seres microscópicos em suas mãos, como também entendem que a sua eliminação diária é um fator importante na prevenção de doenças. O projeto possui também como objetivos o estímulo à educação sanitária da população e a difusão do conhecimento sobre a microbiologia. Para nossos alunos e professores, o projeto estimula a reflexões profundas sobre questões sociais de nosso país e um reconhecimento do papel destes futuros profissionais como veículos transformadores da realidade nacional através da difusão do conhecimento.
Links:
https://instagram.com/microcombate?igshid=axe3ssxnvg3y
Tatiana de Castro Abreu Pinto
tati.micro@gmail.com
Nossa proposta visa unir duas fortes vertentes das Universidades do mundo moderno – socialização e difusão do ensino associado ao processo de internacionalização necessário para a construção de uma universidade de excelência mundialmente reconhecida. Assim, utilizando conhecimento em Microbiologia, pretendemos difundir a ciência com base em materiais e fomento parcial fornecidos pela American Society for Microbiology. Esses materiais serão preparados pelos alunos e professores envolvidos na proposta, tornando o presente projeto também uma fonte potencial de material didático inovador.
Links
https://www.facebook.com/groups/1504457582920590
https://www.facebook.com/divulgamicro
https://www.instagram.com/studentchapter.ufrj/
Marco Antonio Lemos Miguel
marco.miguel@micro.ufrj.br
Atualmente um grande número de atendimentos ambulatoriais no Brasil estão relacionados a doenças contraídas ou agravadas no ambiente doméstico. Entre elas destacam-se as doenças respiratórias e de pele, além das gastrointestinais. Dentro de uma resistência todos os cômodos e áreas apresentam inúmeras fontes conhecidas ou desconhecidas de risco à saúde. O real risco que estas fontes representam podem variar de dados tradicionais que já fazem parte do conhecimento popular, até o mais avançado e atualizado conhecimentos científico, que normalmente estão longe do conhecimento popular ou não utilizam uma linguagem adequada para que o cidadão possa avaliar e decidir a real necessidade de eliminar a fonte do perigo. Conhecer adequadamente estes perigos é suas fontes no lar, que é considerado normalmente um ambiente de segurança, representa uma das principais formas de reduzir os danos causados à saúde da população. Estes danos aumentam os gastos do governo com saúde, além de reduzir a produtividade e a qualidade de vida da população. A difusão destas informações na forma de palestras, oficinas, minicursos e pelas redes sociais na internet.
Alane Beatriz Vermelho
abvermelho@micro.ufrj.br
Este projeto foi iniciado em 2010 e é voltado para a divulgação cientifica junto ao público infantil e leigo. Professores e alunos de pós-graduação visitam escolas, divulgando a Microbiologia e despertando o pensamento científico. O Projeto desenvolve técnicas, materiais didáticos, jogos, plataforma online, aulas e palestras, sobre: educação e divulgação da ciência, conscientização ambiental e saúde humana. Presente nas diversas áreas a Microbiologia é importante para o desenvolvimento econômico e social, incluindo a indústria, medicina, farmácia, biotecnologia e meio ambiente, temas estes comumente abordados pela equipe. A natureza e aplicabilidade nessas áreas serão apresentadas através de personagens que representam os principais grupos de micróbios: bactérias, fungos, leveduras, protozoários, algas microscópicas e vírus. Mediação de leitura, brincadeiras, distribuição de material didático, aulas e observações microscópicas ministram conceitos do cotidiano e saúde. Experimentos simples como a observação do processo de fermentação com fermento de pão, coleta e crescimento de microrganismos do ambiente pelas crianças, lavagem de mão com tinta fluorescente, motivam e incentivam a participação do público, principalmente quando realizadas no laboratório. Discentes internos da UFRJ participarão com visitas e confecção de materiais para a SIAC, Feiras Científicas, assim como aos demais eventos aos quais possamos apresentar nosso projeto, o Hoje Nossa Escola é a Universidade e visitas as escolas federais e municipais do Rio de Janeiro.
Links:
https://www.instagram.com/cienciacommicrobios/
https://www.facebook.com/beatrizvermelho
https://cienciacomicrobios.wixsite.com/projeto
Claudia Neto Paiva cnpaiva@iname.com
Este projeto visa o do ensino de Método Científico, com base na obra de Karl Popper “A lógica da descoberta científica’, sobre uma fruta vermelha que os habitantes de uma cidade acreditavam que era capaz de promover saúde. Com a utilização dessa história, os estudantes do ensino fundamental serão conduzidos a entender o contraste entre a crença dos habitantes de uma cidade e a forma pela qual os cientistas testam essa crença; aprenderá como os cientistas coletam, analisam os dados e refutam hipóteses com base no teste experimental; será apresentado a diferença entre o conceito científico de corroboração de uma hipótese e o conceito leigo de “comprovação”; será convidado a construir novas hipóteses e formas de testá-las, e apresentado à forma como a Ciência trabalha: sem nunca saber se chegou à verdade, mas construindo modelos sobre a natureza que permitem construir tecnologia e transformar o mundo para nosso benefício. Durante as atividades também são contadas histórias conhecidas de descoberta científica, como a descoberta da Doença de Chagas por Carlos Chagas e criação das vacinas. Por fim, é contando um pouco sobre quais as técnicas mais utilizadas em laboratório para o teste de nossas hipóteses. Despois desse encontro os alunos são levados para a UFRJ e esses testes são conduzidos nos laboratórios do Instituto de Microbiologia.
Vagas: 2
Carga horária: 65
Dirlei Nico
dirlei@micro.ufrj.br
Atualmente, a disseminação de informação é feita rapidamente e por pessoas sem conhecimento do assunto e com interesses escusos. Esse cenário se tornou caótico com a pandemia de Covid-19. Qualquer pessoa se tornou especialista e comentarista do tema. Uma enxurrada de notícias sem nenhum fundamento científico, nas quais, se tratava sem nenhum critério ético sobre medicações, tratamentos alternativos e recusa da aplicação das vacinas contra a Covid-19. No ano de 2020, páginas em redes sociais sobre o tema antivacinas, apresentaram cerca de 28 milhões de seguidores com tendência de aumento nesse número. Combater o movimento antivacinas e as “fake news” é uma tarefa complicada, pois uma vez semeada a dúvida, ela ganha espaço sendo difícil reverter a situação. Visamos combater com base científica, notícias falsas e o movimento antivacinas que se tornou um grave risco à saúde global. O programa de imunização brasileiro, criado em 1973, sempre foi um exemplo para outros países. Graças às campanhas de vacinação, doenças graves como o sarampo e a poliomielite foram controladas. A população brasileira aumentou sua expectativa de vida com a imunização contra a gripe. E o combate ao câncer ganhou forças com o auxílio preventivo da vacina contra a hepatite B e contra o HPV. Além disso, a melhoria do cenário epidemiológico da Covid-19 foi evidente com a diminuição de casos graves e mortes por Covid-19 à medida que a imunização da população aumentava.
Maulori Curie Cabral
maulori@micro.ufrj.br
O projeto tem por metas: levar para a população parte do conhecimento científico gerado na Universidade e alcançar mudanças de atitudes, por parte do público atingido, em prol do bem estar coletivo; complementar a formação profissional de alunos da UFRJ pela realização de ações de civilidade e patriotismo; desenvolver o papel social da UFRJ na coletividade; promover a interdisciplinaridade na formação de acadêmicos e estudantes de ensino médio e fundamental e gerar publicações e trabalhos, apresentados em eventos de extensão. São desenvolvidas atividades para serem aplicadas de acordo com a faixa etária do público alvo, em que professores, alunos bolsistas e educandos permutam informações, desenvolvendo assim uma relação de troca mútua, como se espera de atividades extensionistas, tornando o processo de aprendizagem mais motivador, tanto para crianças e adolescentes em idade escolar e seus respectivos professores, como também para adultos em suas comunidades. Os locais de implementação do projeto são bastante diversificados, desde instituições de ensino como Creches, Escolas de Ensino Fundamental, Médio e de Jovens e Adultos (EJA), Universidades, Comunidades, pacificadas ou não, Associações Religiosas, Espaços de Ciência, Encontros promovidos por Secretarias de Estado de Ensino e Saúde, entre outros. A linguagem, sempre que necessário, é adaptada ao público alvo. As apresentações não se restringem ao Município do Rio de Janeiro, atendendo a vários outros municípios do Estado, entre eles, Campos dos Goytacazes, Duque de Caxias, Natividade, Nilópolis, Niterói e Tanguá. As diversas atividades visam a divulgação da Microbiologia e dos fenômenos (benéficos ou patogênicos) presentes na natureza pelo contato com bactérias, fungos e vírus e a importância do comportamento humano na manutenção de condições harmônicas ou não, frente à relação indelével que a humanidade mantém com micróbios e vírus.
Uma das mais solicitadas realizações do projeto consiste do evento denominado Fuzuê da Dengue que, de acordo com o público alvo, o local e o tempo disponíveis, desenvolve uma ou mais das atividades constantes da seguinte programação:
1- Palestra: Dengue: Mitos e verdades;
2- Filmes científicos premiados internacionalmente:
- O mundo macro e micro dos Aedes aegypti;
- Aedes aegypti e Aedes albopictus: uma ameaça nos trópicos.
3- Show dos mosquitos adestrados: Uma maneira lúdica para identificar larvas de A. aegypti;
4- Dramatização da história em quadrinhos ”A Fuga do aegypti”, enfatizando a necessidade de participação integrada da comunidade para eliminação dos mosquitos vetores da dengue;
5- Palestra: Vantagens de utilização de uma Mosquitoeira (Patente UFRJ) e seu correspondente genérico, a Mosquitérica, como armadilha letal para mosquitos;
6- Teatro de fantoches: Kiko e Adriana Galileu na luta contra a dengue ;
7- O Karaokê dos mosquitos;
8- Peça teatral: A máfia dos mosquitos listrados;
9- Oficina: Culto à Cidadania, com o tema “Faça seu vizinho feliz: Tome providências para que ele não pegue dengue. Aprenda como utilizar garrafa pet para confeccionar uma “mosquitoeira genérica” e usá-la como armadilha para eliminar os mosquitos da vizinhança;
10- Oficina: Jogos interativos sobre a dengue e seus vetores (Jogo da memória, Caça palavras, Palavras Cruzadas, Quebra cabeças da dengue, Dominó da dengue, Enigma da dengue e Trilhas);
11- Dança: Participantes são convidados a dançar ao som do Xote da Dengue, especialmente composto para essa atividade, promovendo descontração entre os participantes;
12- Casa anti-dengue: Exposição da maquete de uma casa apresentando todas as condições refratárias ao desenvolvimento de mosquitos. Faz parte do Fuzuê da dengue o atendimento acadêmico à população, tirando dúvidas sobre a dengue, pelo telefone Disque Dengue 2562 6698 e pelo e-mail equipefuzue.ufrj@gmail.com, através dos quais também podem ser solicitadas e marcadas as apresentações da equipe, mediante o fornecimento de transporte pela instituição interessada.
Agnes Marie Sa Figueiredo
agnes@micro.ufrj.br
Atualmente, o aprendizado das ciências no ensino fundamental vem sendo dificultado por uma série de fatores, como a falta de atividades interdisciplinares e interativas. Para suprir essa carência, criamos o evento anual “Hoje nossa Escola é a Universidade”. O evento consiste na transferência física de alunos do quarto e/ou quinto ano de uma escola pública, baseada no Grande Rio, para o Instituto de Microbiologia Paulo de Góes, da UFRJ. Durante todo um dia, os alunos participam de uma série de atividades que giram em torno dos micróbios. Nesse dia, os alunos aprendem ciência a partir do conhecimento cotidiano, abordando os principais temas da microbiologia.

Luciana Barros de Arruda
arruda@micro.ufrj.br
O presente projeto se baseia nas premissas de que a Universidade é uma fonte confiável de informação, e a Escola um potencial agente disseminador de informação, e tem como foco debater sobre doenças infecciosas humanas, e sobre o papel dos cientistas e da sociedade para reduzir o impacto das mesmas na saúde pública. A ação visa apresentar a estudantes de ensino fundamental e médio conceitos básicos de microbiologia, virologia, e imunologia, incluindo a descrição de microrganismos e vírus; sua diversidade no ambiente e o papel das ações antropomórficas nessa distribuição; como podem causar doença humana e as estratégias para prevenção, tratamento, e controle de tais doenças. A estrutura do projeto será baseada em rodas de conversa que objetivam responder às perguntas propostas pelos estudantes, além de explicar notícias cientificamente corretas e esclarecer notícias falsas (“fake news”), veiculadas em qualquer mídia. Os debates serão apoiados pela utilização de vídeos, modelos tridimensionais de vírus e bactérias, além de amostras biológicas fixadas (sem risco infeccioso), confeccionados por estudantes membros da equipe, sob a supervisão do coordenador da ação. Finalmente, além de contribuir para atualização do conteúdo de biologia e ciências, adequados a cada segmento, objetivamos esclarecer a relevância da ciência para o desenvolvimento de ações de saúde pública, e estimular a aproximação entre o cientista e a sociedade, fortalecendo uma inter-relação de confiabilidade.
Karla Rodrigues Miranda
karomir@gmail.com
O projeto visa estimular o pensamento científico baseado em evidências. Nas atividades será demonstrada a presença de microrganismos que compõem a microbiota de diferentes ambientes e discutida a interação entre microrganismos e seu hospedeiro. Serão discutidos métodos de diagnóstico e epidemiologia básica e molecular das doenças infecciosas para o estudo e investigação de eventos causados por microrganismos. Em outra abordagem, será demonstrado como a Microbiologia pode atuar na solução de casos associados a microrganismos como: patógenos como potenciais armas biológicas, infecções e cuidado com a saúde, microbiologia de alimentos e intoxicação alimentar; e a importância do microbioma sob diferentes aspectos.
Coordenadora: Ana Maria Mazotto
anamazotto@micro.ufrj.br
Os microrganismos desempenham importantes papeis na manutenção do ecossistema, na produção de insumos industriais e na saúde humana, entretanto a microbiologia é uma ciência pouco conhecida pela sociedade brasileira. Também os microrganismos e sua diversidade de aplicações são pouco conhecidos, sendo geralmente associados às doenças. Este projeto visa divulgar a microbiologia e os aspectos positivos da interação dos microrganismos com o homem através da produção de alimentos. Pães, queijos, vinhos, cervejas têm sido consumidos por séculos e são produzidos através de biotransformação conduzidas por fungos e bactérias. Atualmente é sabido que os microrganismos também podem ser incorporados nos alimentos como probióticos, trazendo diversos benefícios à saúde humana. Culinária e saúde são dois temas que despertam o interesse público, e podem ser usados na divulgação da microbiologia. Este é o Microzinhando, um projeto que utiliza plataformas digitais para a divulgação de microbiologia através de receitas e matérias sobre alimentação, culinária e saúde.
Links:
https://www.microzinhando.com
https://www.instagram.com/microzinhando/?hl=pt-br
https://www.facebook.com/microzinhando
Iranaia Miranda
iranaiamiranda@micro.ufrj.br
Diferentes iniciativas de apresentação do universo científico e seu retorno para a sociedade são consideradas essenciais na formação dos alunos de ensino médio. A microbiologia apresenta uma interface muito íntima com a sociedade pois convivemos em um mundo repleto de microrganismos que são visualmente invisíveis, mas temos conhecimento notório de sua existência em nosso cotidiano. O curso de “Noções de Microbiologia e imunologia para alunos de ensino médio”, oferecido anualmente no Instituto de Microbiologia (IMPPG) da UFRJ, se propõe a divulgar, motivar e promover a integração acadêmica com a comunidade. Nele os alunos entrarão em contato com o universo da microbiologia através de atividades práticas e interativas apresentadas pelos alunos do Bacharelado em Microbiologia do IMPPG, terão oportunidade de conhecer atividades de pesquisa desenvolvidas no IMPG e conversar com especialistas das áreas sobre curiosidades e também tirar dúvidas. Além disso, quando o curso é oferecido de forma presencial, os alunos têm a oportunidade de realizar as atividades do curso nos laboratórios de práticas, tornando a vivência motivadora para todos envolvidos. Tudo isso, com objetivo de levar ao aluno de ensino médio uma aproximação com o universo microbiológico, fornecendo uma noção da sua diversidade, função, aplicação tecnológica e despertar nos alunos o interesse para a área científico.
Coordenadora: Dirlei Nico
dirlei@micro.ufrj.br
Nossa proposta de projeto de extensão consiste no cultivo orgânico de 3 espécies de plantas medicinais: camomila, capim-limão e espinheira-santa. Que são plantas bastante conhecidas e utilizadas pela população. A espinheira-santa é um dos fitoterápicos contido na lista do SUS, dada a sua imensa aplicação no tratamento de diversas enfermidades. O projeto pretende desenvolver seu projeto piloto em parceria com o Horto da Prefeitura da UFRJ. Após cultivo, nosso objetivo é atrelar o conhecimento popular e o saber científico e disseminar o uso consciente de plantas medicinais sob a forma de infusões no combate às enfermidades. Nossa proposta consta atividades de cultivo, colheita, higienização, armazenamento, preparo das infusões e análise microbiológica de todo o material antes do consumo pelo público alvo. Desse modo, serviremos um produto livre de contaminação microbiana. Serão oferecidas aulas teóricas com base no conhecimento popular e científico das três espécies que iremos trabalhar e serão feitas degustações de infusões em datas agendadas nos Restaurantes Universitários do Campus da Cidade Universitário- Ilha do Fundão. Estaremos sempre focados na restauração e preservação de conhecimentos populares e científicos que não podem ser perdidos com o tempo, através de encontros abertos de degustação, com workshops sobre a cultura popular do cultivo de ervas e a apresentação científica de seus benefícios ou malefícios, elaboração de publicações sobre o tema.
Maria do Socorro Rosa Rodrigues de Carvalho
msrrcarvalho@micro.ufrj.br
O projeto “Pequenas Formas Vivas” objetiva potencializar o processo ativo de ensino-aprendizagem e ampliar o interesse de alunos e da população, de um modo geral, pela Microbiologia por meio de uma abordagem centrada no “aprender a aprender”. Nosso tema de abordagem são “as pequenas formas vivas”, seres vivos tão pequenos, que só podem ser vistos por meio de um equipamento com potentes lentes de aumento, chamado microscópio. Quem são eles? Onde se encontram? Como controlá-los? As ideais e conceitos serão abordados de forma simples e divertidos, usando uma linguagem popular. O objetivo deste projeto é a divulgação do conhecimento científico, especificamente o da Microbiologia. O projeto é a concepção de um novo método de Divulgação Científica, que se baseia no uso de PLATAFORMAS DIGITAIS para o ensino da Microbiologia. Esse modelo de ensino faz com que as pessoas se tornem protagonistas de seu próprio aprendizado. O tema central das postagens será focado em microrganismos de interesse em saúde pública de grande apelo à população. A escolha de PLATAFORMAS DIGITAIS justifica-se pela facilidade de acesso, baixo custo, além de fatores que estimulam discussões construtivas.
Links:
https://instagram.com/pequenasformasvivas?igshid=s2ekt7b5p7lt
Leandro Araújo Lobo
lobol@micro.ufrj.br
A ideia do Microbiando é discutir artigos científicos de ponta em todas as áreas da microbiologia e imunologia. Vamos utilizar uma linguagem bem acessível para destrinchar esses artigos para vocês, mas sem perder o rigor científico e analítico necessário para essa tarefa. Além de discutir artigos nós teremos o quadro Microlitros de Notícias, onde nossos microbiologistas e imunologistas de plantão irão abordar pequenas reportagens e trazer novidades para vocês. No quadro filogenia da Ciência vamos contar um pouco sobre a vida de grandes personalidades que revolucionaram a Microbiologia e Imunologia com suas descobertas.
Links:
http://www.cienciaexplica.com.br/
https://www.facebook.com/microbiando/
https://twitter.com/microbiando
Gabriella da Silva Mendes
gabriella_mendes@micro.ufrj.br
A população de animais em situação de abandono cresce a cada ano, no Brasil, estima-se que existam cerca de 15 milhões de felinos nas ruas. Entretanto, esse cenário está tendendo a melhorar, pois o número de felinos domiciliados também cresceu exponencialmente nos últimos 10 anos. Visto isso, é imprescindível que o conhecimento acerca de mecanismos de controle populacional de colônias e processo de adoção sejam amplamente difundidos para a sociedade. Além disso, o projeto pretende também criar conteúdo digital informativo acerca do tema com diversas abordagens, incluindo também a importância da vacinação, identificação de animais portadores de zoonoses e controle dos mesmos através dos órgãos de saúde públicos e principais cuidados e benefícios ao se adotar um animal em situação de rua.
Coordenação: Gabriella da Silva Mendes
gabriella_mendes@micro.ufrj.br
É um evento anual, interdisciplinar e interprofissional, organizado por alunos de graduação do curso de “Bacharelado em Ciências Biológicas: Microbiologia e Imunologia” desde a fundação do referido curso, a mais de 20 anos. O evento inclui palestras e cursos ministrados por docentes e discentes de diferentes Instituições de Ensino e Pesquisa, profissionais da indústria e propriedade intelectual. Os alunos envolvidos são responsáveis por tudo: programação, reserva de salas, intervalos, certificados, patrocínio, pôsteres, avaliadores e tudo mais. O objetivo do evento é articular o conhecimento produzido na universidade com práticas transformadoras na área de Educação, Saúde e Tecnologia. Apresentar a estudantes, educadores e profissionais da área noções básicas e a evolução do ensino em Microbiologia visando a geração de conhecimento na área, fundamentais para o entendimento do homem e seu ambiente, higiene e saúde pública, ética e biossegurança em ciências biológicas, e a importância da biotecnologia e inovação para o progresso da ciência e da sociedade Promover integração acadêmica entre os alunos de graduação do referido curso com alunos e discentes de outras unidades acadêmicas e instituições de pesquisa. Além da integração com outros membros da sociedade visando apresentar aos próprios alunos, estudantes e educadores de escolas de ensino médio as opções de carreira acadêmica, tecnológica ou empresarial Introduzir aos alunos as estratégias para organização de Eventos e Reuniões Científicas Promover a capacidade de apresentação de trabalhos científicos através de apresentação de pôsteres e estimular a participação dos estudantes através de premiações Estimular os estudantes participantes do evento ao conhecimento científico e tecnológico e integração com a sociedade.
Raquel Regina Bonelli
raquel.bonelli@micro.ufrj.br
A Semana Mundial de Conscientização sobre o Uso de Antimicrobianos, tradução de “World Antimicrobial Awareness Week (WAAW)” é um evento internacional anualmente promovido pela Organização Mundial da Saúde e outras entidades, com o objetivo de promover educação para o tema da resistência aos antimicrobianos em todas as esferas da sociedade. O Instituto de Microbiologia Paulo de Góes possui especialistas na área e pode ser um importante ator nesta iniciativa, contribuindo para as atividades previstas para esta semana em nível nacional. Assim, o presente evento tem como objetivo realizar ações a serem desenvolvidas na WAAW. Pretendemos atuar em duas principais frentes: (i) preparar material em português para ser utilizado nas redes sociais do projeto (@sos_antibioticos no Instagram e @antibioticoSOS no Twitter) nas semanas que antecedem o evento e na semana do evento propriamente dita; e (ii) atuar junto a turmas do primeiro ano do ensino médio de uma escola em uma atividade didática integrativa que envolve sensibilização, pesquisa e apresentação dos alunos. Acreditamos que a compreensão do fenômeno da resistência leva a um maior engajamento dos indivíduos nas ações necessárias para sua mitigação e queremos, como Universidade, contribuir para que isto ocorra, atuando junto às novas gerações e contando com a força das redes sociais.